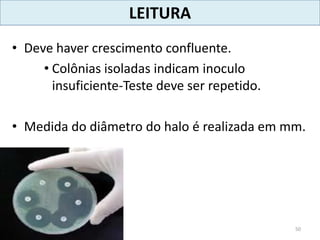
LEITURA
• Deve haver crescimento confluente.
• Colônias isoladas indicam inoculo
insuficiente-Teste deve ser repetido.
• Medida do diâmetro do halo é realizada em mm.
50

1) O documento discute conceitos básicos sobre antimicrobianos, incluindo suas propriedades, mecanismos de ação e exemplos de diferentes classes. 2) É detalhado os mecanismos de ação de vários antimicrobianos, como aqueles que interferem na síntese da parede celular, membrana, proteínas e ácidos nucleicos. 3) Propriedades desejáveis para um agente antimicrobiano são descritas, como toxicidade seletiva, espectro de ação e capacidade de evitar resistência bacteriana.